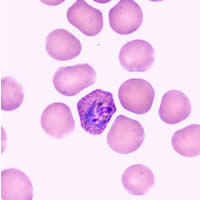
Case 83 Image A
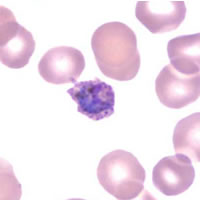
Case 83 Image B
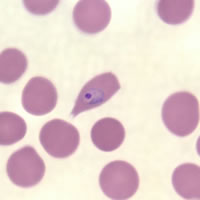
Case 83 Image C
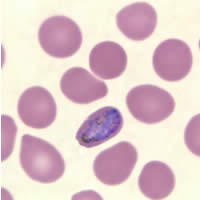
Case 83 Image D

Answer
to Case 83
This was a case of malaria caused by Plasmodium ovale. The diagnostic
features observed were:
- Trophozoites with sturdy chromatin were observed in enlarged red blood cells containing Schüffner's dots (Figures A and B).
- Rings were observed in red blood cells which were oval, enlarged, and fimbriated (Figure C).
- Round to oval gametocytes were found filling the red blood cells, which were enlarged and contained Schüffner's dots (Figure D).
|
|
| A | B |
|
|
| C | D |